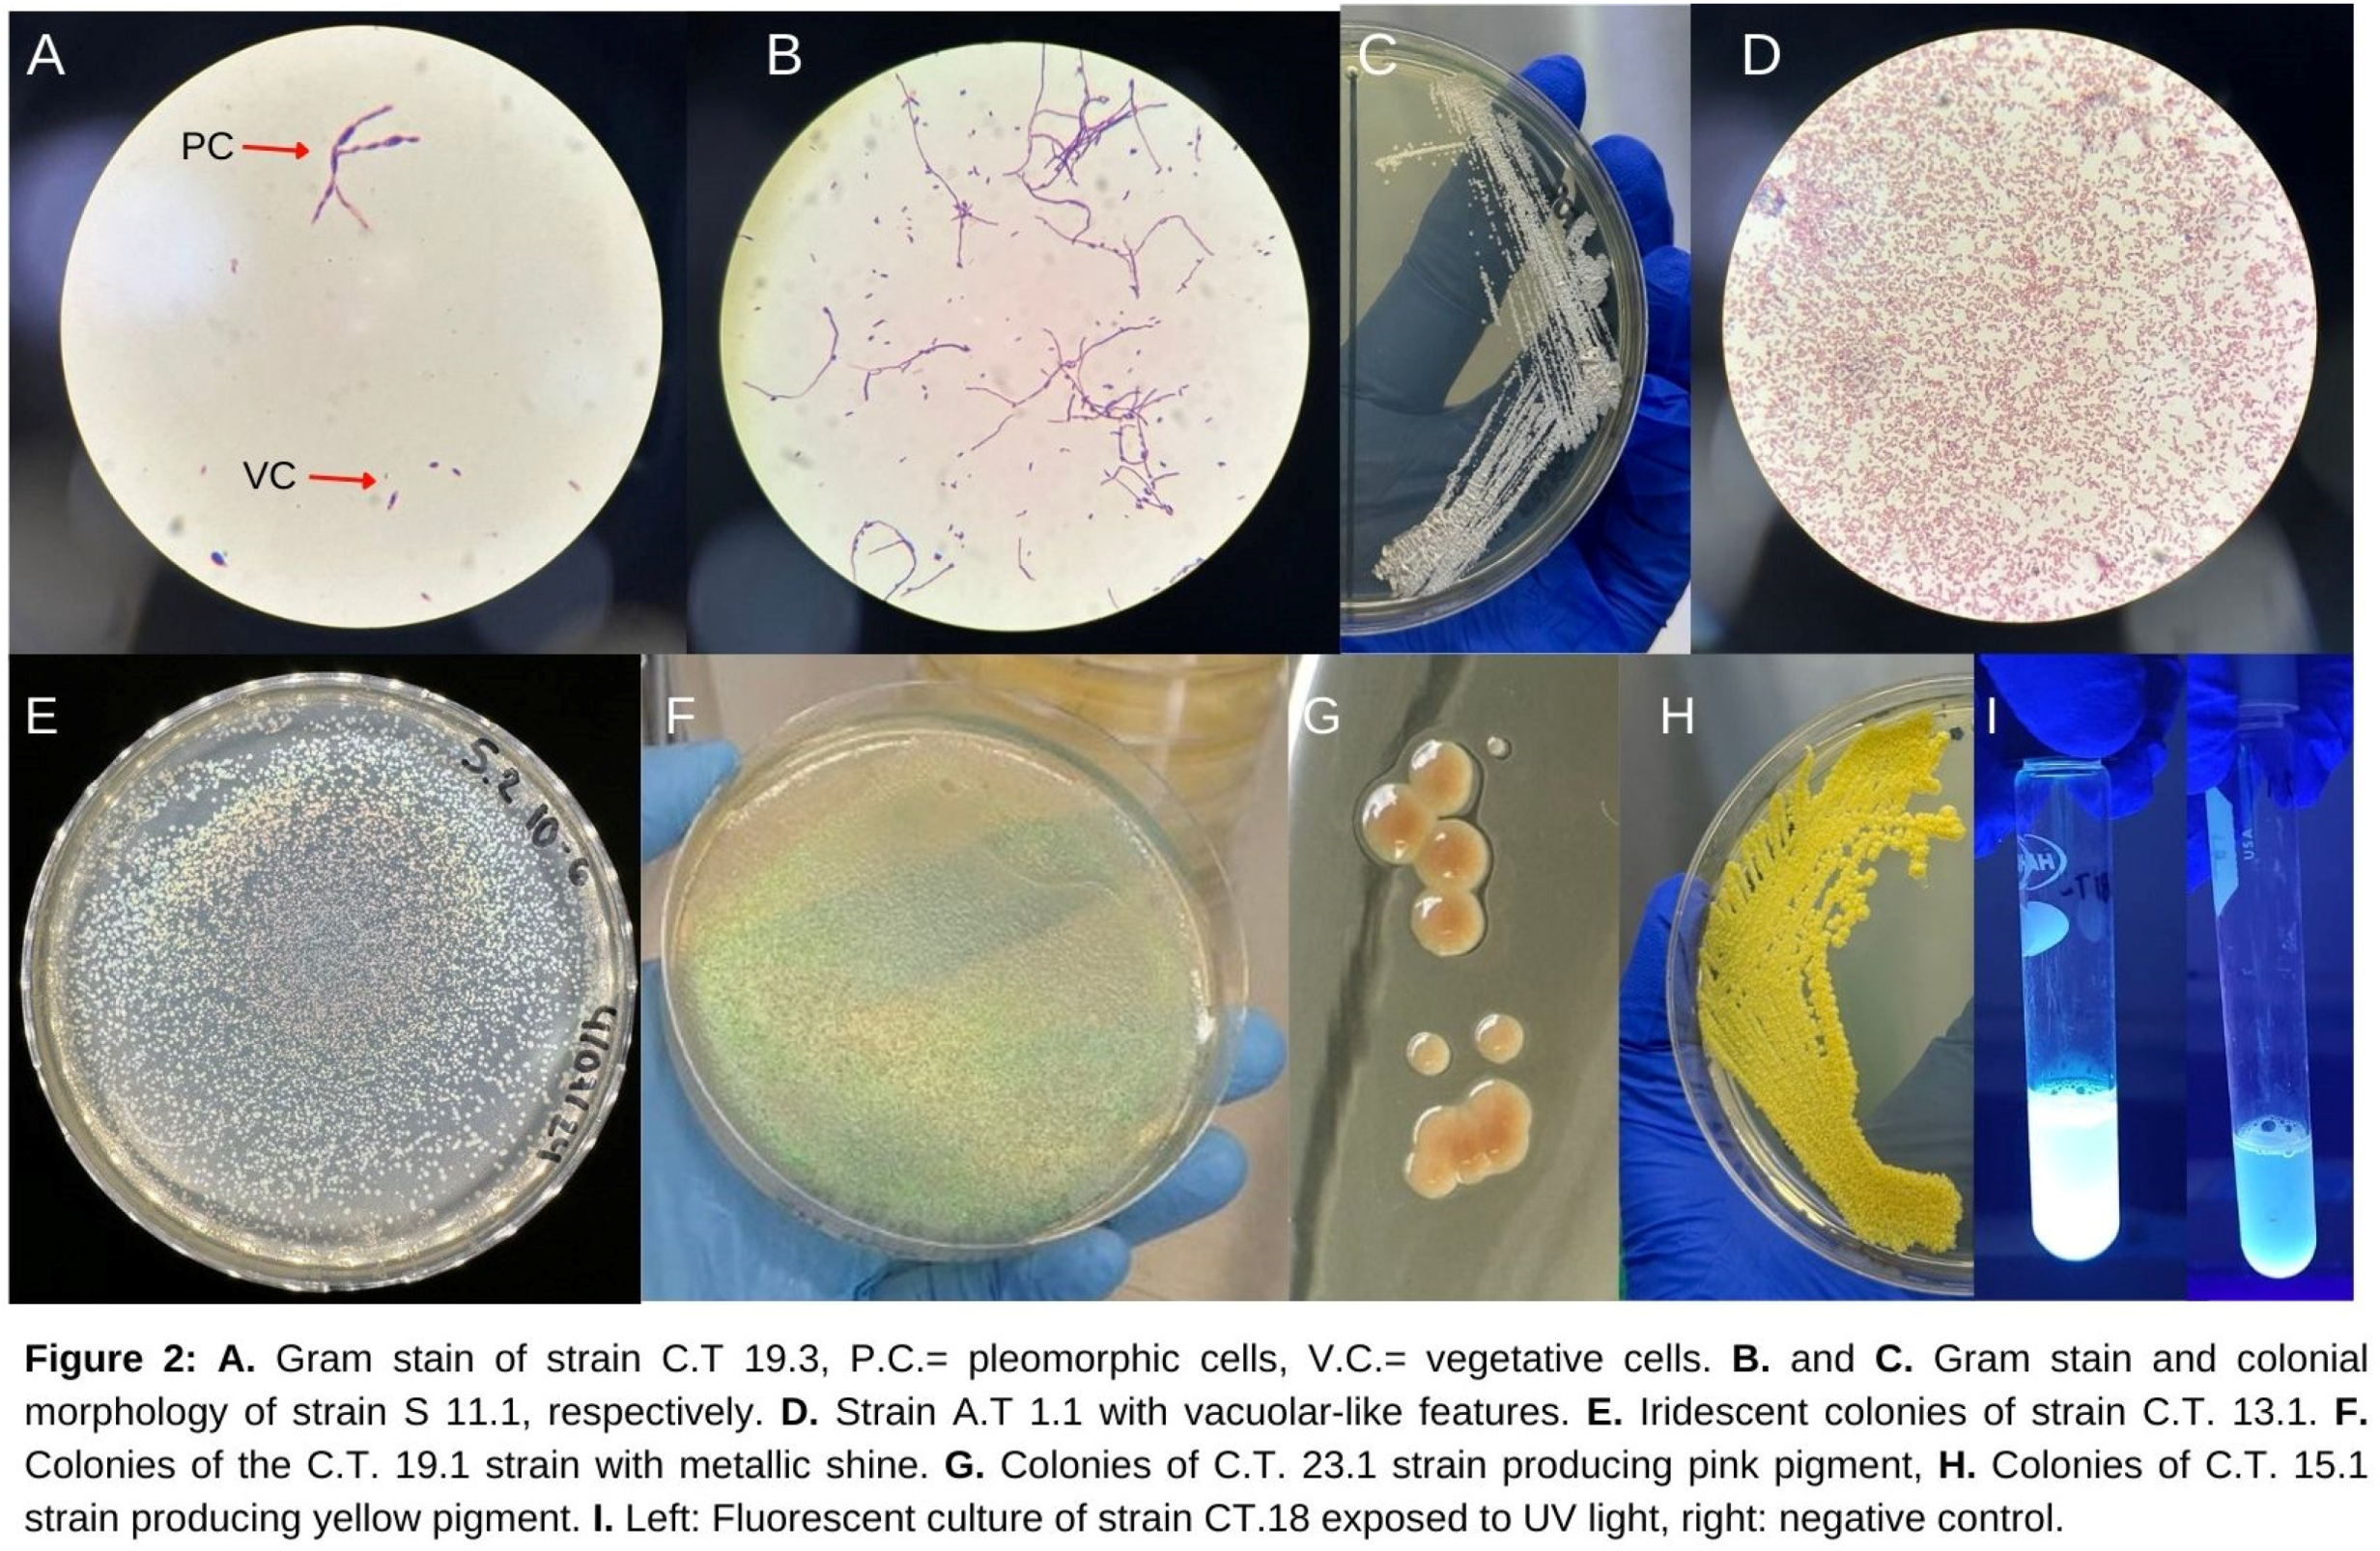
Preprints 145763 g002

Submitted:
10 January 2025
Posted:
13 January 2025
You are already at the latest version
Abstract
Biotechnology provides sustainable solutions for soil and ecological deterioration resulting from human activities. This study investigated the biotechnological potential of strains isolated from environmental samples collected in protected areas and mines of Honduras, focusing on their application for producing biofertilizers and bioremediation. 63 samples were collected from: soil, soil covers, mine waters, and hot springs. From these, 118 bacterial strains were isolated and characterized using microbiological and molecular techniques. The genera Pseudomonas, Bacillus, Azospirillum, and Azotobacter were associated with some of the isolated strains and stood out for their ability to solubilize potassium, fix nitrogen and produce bioactive compounds. Isolates related to bacteria of the genera Bacillus and Pseudomonas demonstrated potential use in biotechnology. Furthermore, some strains exhibited significant genetic diversity and biological similarity to bacterial genera and species utilized in pollution remediation and soil fertility improvement. A small group shows atypical morphologies, including pleomorphic, filamentous structures, features with vacuole-like traits, pigment production, iridescence, and metallic sheen. These results highlight the microbial biodiversity present in soil covers of protected Honduran ecosystems and their importance as reservoirs of microorganisms with biotechnological applications. This study emphasizes the importance of preserving these natural regions, not only for biodiversity preservation but also for utilizing their potential in formulating sustainable solutions to environmental and agricultural challenges.
Keywords:
1. Introduction
2. Materials and Methods
3. Result
4. Discussion
5. Conclusions
Author Contributions
Funding
Acknowledgments
Conflicts of Interest
References
- FAO; UNEP. Summary for policy makers GLOBAL ASSESSMENT OF SOIL POLLUTION [Internet]. Rome, Italy; 2021 [cited 2024 Dec 8]. Available from: https://openknowledge.fao.org/handle/20.500.14283/cb4827en.
- Steffan, J.J.; Brevik, E.C.; Burgess, L.C.; Cerdà, A. The effect of soil on human health: an overview. Eur. J. Soil Sci. 2018, 69, 159–171. [Google Scholar] [CrossRef] [PubMed]
- Shetty, S.S.; D, D.; S, H.; Sonkusare, S.; Naik, P.B.; N, S.K.; Madhyastha, H. Environmental pollutants and their effects on human health. Heliyon 2023, 9, e19496. [Google Scholar] [CrossRef]
- Zhang, X.; He, L.; Yang, X.; Gustave, W. Editorial: Soil pollution, risk assessment and remediation. Front. Environ. Sci. 2023, 11, 1252139. [Google Scholar] [CrossRef]
- Pirttilä, A.M.; Tabas, H.M.P.; Baruah, N.; Koskimäki, J.J. Biofertilizers and Biocontrol Agents for Agriculture: How to Identify and Develop New Potent Microbial Strains and Traits. Microorganisms 2021, 9, 817. [Google Scholar] [CrossRef]
- Minuț, M.; Diaconu, M.; Roșca, M.; Cozma, P.; Bulgariu, L.; Gavrilescu, M. Screening of Azotobacter, Bacillus and Pseudomonas Species as Plant Growth-Promoting Bacteria. Processes 2022, 11, 80. [Google Scholar] [CrossRef]
- Olajide, P.O.; Adeloye, A.O. Hydrocarbon biodegradation by Proteus and Serratia strains isolated from oil-polluted water in Bonny Community, Niger Delta, Nigeria. Results Chem. 2022, 5. [Google Scholar] [CrossRef]
- Dourado, M.N.; Aparecida Camargo Neves, A.; Santos, D.S.; Araújo, W.L. Biotechnological and Agronomic Potential of Endophytic Pink-Pigmented Methylotrophic Methylobacterium spp. Biomed Res Int. 2015, 2015, 1–19. [Google Scholar] [CrossRef] [PubMed]
- Kebede, G.; Tafese, T.; Abda, E.M.; Kamaraj, M.; Assefa, F. Factors Influencing the Bacterial Bioremediation of Hydrocarbon Contaminants in the Soil: Mechanisms and Impacts. J. Chem. 2021, 2021, 1–17. [Google Scholar] [CrossRef]
- Gilcreas, F.W. Standard Methods for the Examination of Water and Waste Water. Am. J. Public Health Nations Health 1966, 56, 387–388. [Google Scholar] [CrossRef]
- Romero-Perdomo, F.; Abril, J.; Camelo, M.; Moreno-Galván, A.; Pastrana, I.; Rojas-Tapias, D.; Bonilla, R. Azotobacter chroococcum as a potentially useful bacterial biofertilizer for cotton (Gossypium hirsutum): Effect in reducing N fertilization. Rev. Argent. de Microbiol. 2017, 49, 377–383. [Google Scholar] [CrossRef] [PubMed]
- Rajawat, M.V.S.; Singh, S.; Tyagi, S.P.; Saxena, A.K. A Modified Plate Assay for Rapid Screening of Potassium-Solubilizing Bacteria. Pedosphere 2016, 26, 768–773. [Google Scholar] [CrossRef]
- Atashpaz, S.; Khani, S.; Barzegari, A.; Barar, J.; Vahed, S.Z.; Azarbaijani, R.; Omidi, Y. A robust universal method for extraction of genomic DNA from bacterial species. Microbiology 2010, 79, 538–542. [Google Scholar] [CrossRef]
- İnceoǧlu, O.; Hoogwout, E.F.; Hill, P.; van Elsas, J.D. Effect of DNA Extraction Method on the Apparent Microbial Diversity of Soil. Appl Environ Microbiol. 2010, 76, 3378–3382. [Google Scholar] [CrossRef]
- Anyi, U.; New, C.; Chai, L.; Loo, Y.; Nor Khaizura, M.A.R.; Kayali, A.; Radu, S. Prevalence of Bacillus cereus s.l. in ultra-high temperature chocolate milk from selected milk manufacturers in Malaysia. Food Res. 2020, 4, 982–990. [Google Scholar] [CrossRef] [PubMed]
- Chauhan, P.; Sharma, N.; Tapwal, A.; Kumar, A.; Verma, G.S.; Meena, M.; Seth, C.S.; Swapnil, P. Soil Microbiome: Diversity, Benefits and Interactions with Plants. Sustainability 2023, 15, 14643. [Google Scholar] [CrossRef]
- Song, Y.; Yao, S.; Li, X.; Wang, T.; Jiang, X.; Bolan, N.; Warren, C.R.; Northen, T.R.; Chang, S.X. Soil metabolomics: Deciphering underground metabolic webs in terrestrial ecosystems. Eco-Environment Heal. 2024, 3, 227–237. [Google Scholar] [CrossRef]
- Murúa, J.M.; Gaxiola, A. Variability in terrestrial litter decomposition can be explained by nutrient allocation strategies among soil decomposer communities. Funct. Ecol. 2023, 37, 1642–1652. [Google Scholar] [CrossRef]
- Kientz, B.; Luke, S.; Vukusic, P.; Péteri, R.; Beaudry, C.; Renault, T.; Simon, D.; Mignot, T.; Rosenfeld, E. A unique self-organization of bacterial sub-communities creates iridescence in Cellulophaga lytica colony biofilms. Sci. Rep. 2016, 6, 19906–19906. [Google Scholar] [CrossRef]
- Kientz, B.; Vukusic, P.; Luke, S.; Rosenfeld, E. Iridescence of a Marine Bacterium and Classification of Prokaryotic Structural Colors. Appl. Environ. Microbiol. 2012, 78, 2092–2099. [Google Scholar] [CrossRef]
- Hegazy, A.A.; Abu-Hussien, S.H.; Elsenosy, N.K.; El-Sayed, S.M.; El-Naga, M.Y.A. Optimization, characterization and biosafety of carotenoids produced from whey using Micrococcus luteus. BMC Biotechnol. 2024, 24, 1–17. [Google Scholar] [CrossRef] [PubMed]
- Tizabi, D.; Hill, R.T. Micrococcus spp. as a promising source for drug discovery: A review. J. Ind. Microbiol. Biotechnol. 2023, 50. [Google Scholar] [CrossRef] [PubMed]
- Harumain, Z.A.S.; Mohamad, M.A.N.; Nordin, N.F.H.; Shukor, M.Y.A. Biodegradation of Petroleum Sludge by Methylobacterium sp. Strain ZASH. Trop. Life Sci. Res. 2023, 34, 197–222. [Google Scholar] [CrossRef] [PubMed]
- Torres Vera, R.; Bernabé García, A.J.; Carmona Álvarez, F.J.; Martínez Ruiz, J.; Fernández Martín, F. Application and effectiveness of Methylobacterium symbioticum as a biological inoculant in maize and strawberry crops. Folia Microbiol (Praha) 2024, 69, 121–131. [Google Scholar] [CrossRef] [PubMed]
- Arrobas, M.; Correia, C.M.; Rodrigues, M.Â. Methylobacterium symbioticum Applied as a Foliar Inoculant Was Little Effective in Enhancing Nitrogen Fixation and Lettuce Dry Matter Yield. Sustainability 2024, 16, 4512. [Google Scholar] [CrossRef]
- Zhang, G.; Yang, Y.; Wang, S.; Sun, Z.; Jiao, K. Alkalimicrobium pacificum gen. nov., sp. nov., a marine bacterium in the family Rhodobacteraceae. Int. J. Syst. Evol. Microbiol. 2015, 65, 2453–2458. [Google Scholar] [CrossRef]
- Irgens, R.L.; Gosink, J.J.; Staley, J.T. Polaromonas vacuolata gen. nov., sp. nov., a Psychrophilic, Marine, Gas Vacuolate Bacterium from Antarctica. Int. J. Syst. Evol. Microbiol. 1996, 46, 822–826. [Google Scholar] [CrossRef]
- Ruan, C.-J.; Zheng, X.-W.; Wang, J.; Song, L.; Zhu, Y.-X.; Du, W.-B.; Lu, Z.-J.; Huang, Y.; Huang, L.; Dai, X. Hyphobacterium indicum sp. nov., isolated from deep seawater, and emended description of the genus Hyphobacterium. Int. J. Syst. Evol. Microbiol. 2018, 68, 3760–3765. [Google Scholar] [CrossRef]
- Zhao, S.b.; Liu, L.; Lian, F.B.; Du, Z.J. Hyphobacterium marinum sp. nov. and Hyphobacterium lacteum sp. nov., isolated from marine sediment. Int J Syst Evol Microbiol. 2024, 74. [Google Scholar] [CrossRef] [PubMed]
- Martineau, C.; Villeneuve, C.; Mauffrey, F.; Villemur, R. Hyphomicrobium nitrativorans sp. nov., isolated from the biofilm of a methanol-fed denitrification system treating seawater at the Montreal Biodome. Int. J. Syst. Evol. Microbiol. 2013, 63, 3777–3781. [Google Scholar] [CrossRef] [PubMed]
- Martineau, C.; Mauffrey, F.; Villemur, R. Comparative Analysis of Denitrifying Activities of Hyphomicrobium nitrativorans, Hyphomicrobium denitrificans, and Hyphomicrobium zavarzinii. Appl. Environ. Microbiol. 2015, 81, 5003–5014. [Google Scholar] [CrossRef] [PubMed]
- Pol, A.; Op den Camp, H.J.M.; Mees, S.G.M.; Kersten, M.A.S.H.; van der Drift, C. Isolation of a dimethylsulfide-utilizing Hyphomicrobium species and its application in biofiltration of polluted air. Biodegradation 1994, 5, 105–112. [Google Scholar] [CrossRef]
- Martineau, C.; Mauffrey, F.; Villemur, R. Comparative Analysis of Denitrifying Activities of Hyphomicrobium nitrativorans, Hyphomicrobium denitrificans, and Hyphomicrobium zavarzinii. Appl. Environ. Microbiol. 2015, 81, 5003–5014. [Google Scholar] [CrossRef] [PubMed]
- Li, J.; Törkel, K.; Koch, J.; Tanabe, T.S.; Hsu, H.Y.; Dahl, C. In the Alphaproteobacterium Hyphomicrobium denitrificans SoxR Serves a Sulfane Sulfur-Responsive Repressor of Sulfur Oxidation. Antioxidants 2023, 12, 1620. [Google Scholar] [CrossRef]
- Thu, A.M.; Alam, S.M.; Khan, M.A.; Han, H.; Liu, D.-H.; Tahir, R.; Ateeq, M.; Liu, Y.-Z. Foliar spraying of potassium sulfate during fruit development comprehensively improves the quality of citrus fruits. Sci. Hortic. 2024, 338. [Google Scholar] [CrossRef]
- Simon, C.A.; Kayode, P.B. Nitrogen and potassium fertilizer influenced nutrient use efficiency and biomass yield of two plantain (Musa spp. AAB) genotypes. Afr. J. Agric. Res. 2015, 10, 458–471. [Google Scholar] [CrossRef]
- Al-Karablieh, N.; Al-Shomali, I.; Al-Elaumi, L.; Hasan, K. Pseudomonas fluorescens NK4 siderophore promotes plant growth and biocontrol in cucumber. J. Appl. Microbiol. 2022, 133, 1414–1421. [Google Scholar] [CrossRef] [PubMed]
- Wu, X.; Wang, X.; Meng, H.; Zhang, J.; Lead, J.R.; Hong, J. Pseudomonas fluorescens with Nitrogen-Fixing Function Facilitates Nitrogen Recovery in Reclaimed Coal Mining Soils. Microorganisms 2023, 12, 9. [Google Scholar] [CrossRef]
- Wang, Z.; Chen, X.; Zhong, T.; Li, B.; Yang, Q.; Du, M.; Zalán, Z.; Kan, J. Bioeffector Pseudomonas fluorescens ZX Elicits Biosynthesis and Accumulation of Functional Ingredients in Citrus Fruit Peel: A Promising Strategy for a More Sustainable Crop. J. Agric. Food Chem. 2021, 69, 13810–13820. [Google Scholar] [CrossRef]
- Sah, S.; Krishnani, S.; Singh, R. Pseudomonas mediated nutritional and growth promotional activities for sustainable food security. Curr. Res. Microb. Sci. 2021, 2, 100084. [Google Scholar] [CrossRef] [PubMed]
- Mudi, L.; Muhidin; Rakian, T.C.; Sutariati, G.A.K.; Leomo, S.; Yusuf, D.N. Effectivity of Pseudomonas fluorescens TBT214 in increasing soybean seed quality in different seed vigor. IOP Conf Ser Earth Environ Sci. 2021, 807, 042069. [Google Scholar] [CrossRef]
- Chitra, P.; Jijeesh, C.M. Biopriming of seeds with plant growth promoting bacteria Pseudomonas fluorescens for better germination and seedling vigour of the East Indian sandalwood. New For. 2021, 52, 829–841. [Google Scholar] [CrossRef]
- Prusty, S.; Sahoo, R.K.; Sharaya, R.; Tuteja, N.; Gill, S.S. Unraveling the potential of native Azotobacter and Azospirillum spp. formulations for sustainable crop production of rice (Oryza sativa L. var. Khandagiri). South Afr. J. Bot. 2023, 162, 10–19. [Google Scholar] [CrossRef]
- Naqqash, T.; Malik, K.A.; Imran, A.; Hameed, S.; Shahid, M.; Hanif, M.K.; Majeed, A.; Iqbal, M.J.; Qaisrani, M.M.; van Elsas, J.D. Inoculation with Azospirillum spp. Acts as the Liming Source for Improving Growth and Nitrogen Use Efficiency of Potato. Front. Plant Sci. 2022, 13, 929114. [Google Scholar] [CrossRef] [PubMed]
- Sumbul, A.; Ansari, R.A.; Rizvi, R.; Mahmood, I. Azotobacter: A potential bio-fertilizer for soil and plant health management. Saudi J. Biol. Sci. 2020, 27, 3634–3640. [Google Scholar] [CrossRef] [PubMed]
- Rocco, D.H.E.; Freire, B.M.; Oliveira, T.J.; Alves, P.L.M.; Júnior, J.M.d.O.; Batista, B.L.; Grotto, D.; Jozala, A.F. Bacillus subtilis as an effective tool for bioremediation of lead, copper and cadmium in water. Discov. Appl. Sci. 2024, 6, 1–10. [Google Scholar] [CrossRef]
- Arce-Inga M, González-Pérez AR, Hernandez-Diaz E, Chuquibala-Checan B, Chavez-Jalk A, Llanos-Gomez KJ, et al. Bioremediation Potential of Native bacillus sp. Strains as a Sustainable Strategy for Cadmium Accumulation of Theobroma cacao in Amazonas Region. Microorganisms 2022, 10, 2108. [Google Scholar] [CrossRef] [PubMed]
- Das, A.; Das, N.; Rajkumari, J.; Pandey, P.; Pandey, P. Exploring the bioremediation potential of Bacillus spp. for sustainable mitigation of hydrocarbon contaminants. Environ. Sustain. 2024, 7, 135–156. [Google Scholar] [CrossRef]
- Golnari, M.; Bahrami, N.; Milanian, Z.; Khorasgani, M.R.; Asadollahi, M.A.; Shafiei, R.; Fatemi, S.S.-A. Isolation and characterization of novel Bacillus strains with superior probiotic potential: comparative analysis and safety evaluation. Sci. Rep. 2024, 14, 1–11. [Google Scholar] [CrossRef]
- Hussein, M.H.; Saeed, I.O. Isolation, Identification Bacteria and Bioremediation of Soil Contaminate Crude Oil from Specific Area (Baiji_Iraq). J. Res. Appl. Sci. Biotechnol. 2022, 1, 187–193. [Google Scholar] [CrossRef]

| Sample ID | Carbohydrate Fermentation |
Motility |
Indole test | Ornithine decarboxylation | Growth in NaCl 6.5% |
Citrate Usage | NO3 Reduction | ||||||
| Xylose | Mannitol | Saccharose | Maltose | Glucose | Lactose | Arabinose | |||||||
| CT.11.1 | - | + | - | + | + | - | - | + | + | + | + | + | + |
| S.5.3 | + | + | + | + | + | - | + | + | + | - | + | - | + |
| S.26.2 | + | - | - | + | + | - | + | + | + | - | - | + | - |
| AT.5.3 | - | + | + | + | + | - | + | + | + | - | + | + | + |
| CT.4.2 | - | + | + | + | + | - | - | + | + | - | + | + | + |
| CT.15.3 | + | - | + | + | - | - | + | - | - | - | - | + | - |
| CT.5.1 | + | + | + | + | + | - | - | + | + | - | - | + | + |
| CT.12.1 | + | - | + | - | + | - | - | - | - | - | - | + | - |
| CT.18.1 | + | + | - | - | + | - | - | + | - | - | + | + | + |
| CT.6.1 | + | + | + | - | + | - | - | + | - | - | + | + | + |
| S.7.2 | + | - | - | - | - | - | + | - | - | - | - | + | - |
| CT.6.2 | - | + | + | + | + | - | - | + | + | - | + | + | + |
Disclaimer/Publisher’s Note: The statements, opinions and data contained in all publications are solely those of the individual author(s) and contributor(s) and not of MDPI and/or the editor(s). MDPI and/or the editor(s) disclaim responsibility for any injury to people or property resulting from any ideas, methods, instructions or products referred to in the content. |
© 2025 by the authors. Licensee MDPI, Basel, Switzerland. This article is an open access article distributed under the terms and conditions of the Creative Commons Attribution (CC BY) license (http://creativecommons.org/licenses/by/4.0/).
